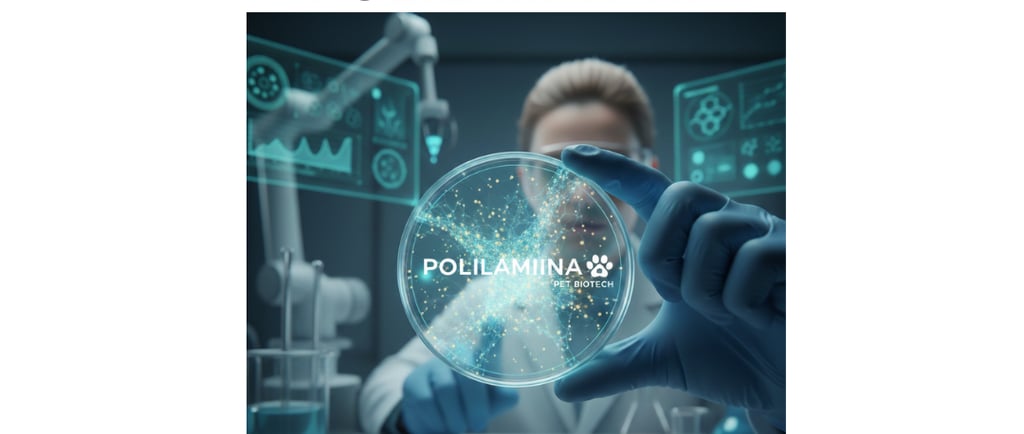

🐾 Inovação no Mundo Pet: Como a Polilaminina está mudando o futuro da Medicina Veterinária
@Vet_glausen
2/21/20262 min read

🐾 Inovação no Mundo Pet: Como a Polilaminina está mudando o futuro da Medicina Veterinária
Você já ouviu falar em Polilaminina? Embora o nome pareça saído de um filme de ficção científica, essa tecnologia já é uma realidade que promete revolucionar a saúde dos nossos melhores amigos.
Na intersecção entre a biotecnologia e o bem-estar animal, a polilaminina surge como uma peça-chave para tratamentos mais eficazes e, acima de tudo, mais éticos.
O que é a Polilaminina?
De forma simples, a polilaminina é um material que "imita" a estrutura natural do corpo. Ela funciona como um andaime (ou um "tapete mágico") que ajuda as células a crescerem e se comunicarem de forma saudável em laboratório.
Diferente das proteínas comuns que perdem a força rapidamente, a polilaminina é estável e cria um ambiente 3D perfeito para o desenvolvimento de células-tronco e neurônios.
3 Impactos Reais para o Mundo Pet
1. Tratamento de Doenças Neurológicas em Cães e Gatos Muitos pets sofrem com lesões de coluna ou doenças degenerativas. Com a polilaminina, cientistas conseguem cultivar células nervosas de forma muito mais eficiente. Isso abre portas para terapias regenerativas que podem, no futuro, ajudar animais que perderam a mobilidade a voltarem a andar.
2. Medicina Personalizada (Testes sem Sofrimento) Imagine testar se um novo remédio funciona para o seu cachorro antes mesmo de ele tomar a primeira dose. Através do cultivo celular em polilaminina, é possível criar modelos de tecidos do próprio animal em laboratório. Isso reduz a necessidade de testes invasivos e garante que o tratamento seja o mais certeiro possível.
3. O Compromisso com o ESG e a Ética Animal Para empresas e tutores que prezam por práticas sustentáveis e éticas (o famoso ESG), a polilaminina é uma aliada poderosa. Ela permite o avanço da ciência reduzindo drasticamente a dependência de modelos animais tradicionais em pesquisas laboratoriais. É a tecnologia trabalhando para salvar vidas, sem sacrificar outras.
Por que isso importa hoje?
O mercado pet não é mais apenas sobre ração e banho; é sobre longevidade e qualidade de vida. Adotar ou apoiar tecnologias que buscam biomimetismo (imitar a natureza) mostra que a medicina veterinária está alcançando o mesmo patamar de excelência da medicina humana.
Nota de Rodapé: Na nossa empresa, acreditamos que a inovação só faz sentido se for acompanhada de responsabilidade social e cuidado com o meio ambiente. A biotecnologia aplicada ao mundo pet é o exemplo vivo de que o futuro pode ser mais tecnológico e, ao mesmo tempo, mais humano.
Gostou deste mergulho na ciência veterinária? Compartilhe este post com aquele amigo que ama tecnologia e não abre mão do bem-estar do seu pet!
SIGA A GENTE
Contato
Newsletter
glausenlima@gmail.com
(31)999492970
© 2024. Todos os direitos reservados.
